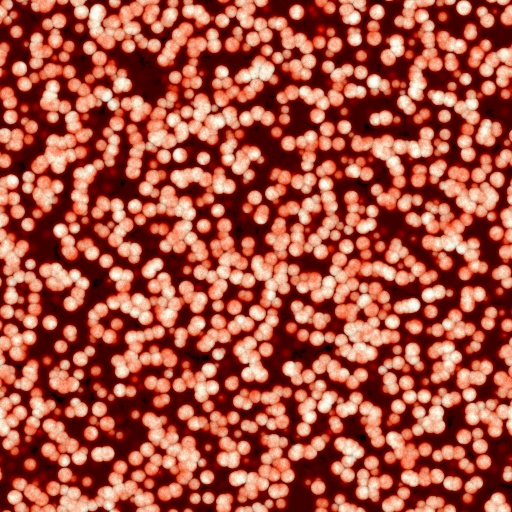
Diffuse Map

szi_acneoverkill
By szistvan
“szi_acneoverkill” is one of 7373 texture filters in Filter Forge – mighty graphics software for Windows and Mac with thousands of photo effects and seamless textures, and a visual editor to create custom filters. All textures in Filter Forge are procedural, resolution-independent, and can be seamless. You can change the look of this texture using the filter settings, browse through its 30,000 randomized variations, and render texture maps for game engines. Download Filter Forge to use this texture.
To open this filter, you must have Filter Forge 1.0 or higher installed on your computer. If you don't have it installed yet, click here to download Filter Forge.
Save $30 quarterly
Save $30 quarterly